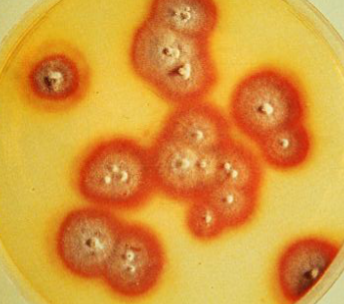
<p>Trichophyton rubrum</p>

1/160
Looks like no tags are added yet.
Name | Mastery | Learn | Test | Matching | Spaced | Call with Kai |
|---|
No analytics yet
Send a link to your students to track their progress
Why fungi is good
some are microbiota/commensal, antiobiotics/penicillin
Fungi species that cause human disease/infection
300 species
teleomorph, perfect
sexual, meiotic
anamorph, imperfect
asexual, mitotic
Fungi phylogeny
eukaryotes, closer to animals phylogenetically
order of classification
kingdom → phylum → genus → species
fungi composition
rigid cell walls containing chitin, many have ergosterol in their cell membrane
three phylum of fungi
ascomycota, basidiomycota, mucormycota(zygomycetes)
deuteromycetes
fungi imperfecti, only reproduce asexually
fungal properties
contain organelles, heterotrophic, osmiotrophs
heterotrophic
requires organic compounds for energy and carbons sources, uses exoenzymes to digest then ingest
osmiotrophs
obtain nutrients by absorption
fungal life style/nutritional modes
saprobes(live on dead materials), parasites, mutualists
mold morphology
multicellular, grow in microscopic filaments(hyphae)
hyphae characteristics
apical growth, tangle together to form larger mass(mycelium)
spitzenkorper
special organelle for hyphal apical growth
septate vs aseptate
septate has sections, aseptate has none
hyaline vs dematiaceous hyphae
hyaline is clear, dematiaceous is pigmented
thermally dimorphic
fungal form changes based on temperature
yeast reproduction
usually asexual, budding(asym), fission(symm)
mold reproduction
sexual spores(meiosis), asexual spores(mitotic)(disease causing)
Conidia
Ascomycetes and basidiomycetes: asexual spores produced on ends of specialized hyphae(conidiophores) and released from tip or side of hyphae
sporangiospores
mucormycetes: asexual spores produced in a specialized sac/capsule(sporangia)
vegetative hyphae
hyphae that fgathers nutrients, located below soil or under agar
aerial hyphae
hyphae that can become reproduction form, located above soil or above agar
fungal cell wall
defined by chitin, can be immunogenic, immunopathogenic, immunomodulatory
immunogenic
elicits immune response
immunopathogenic
response contributes to development of disease
immunomodulatory
changes way immune system responds
fungi commensals
GI: Candida
outer skin: Malassezia
Respiratory tract: pneumocystis jirovecii
Fungi general concepts
slow growers and movers, many can invade into tissue/vessels, many commensals, cryptococcus is an opportunistic and primary pathogen
mycotoxicosis
a toxin in grains, corn, nuts, associated with liver cancer, aflatoxin(aspergillus flavus)
ergotism symptoms
vomit, diarrhea, hallucinations, gangrene
causes for increases in fungal infections
HIV/AIDS pandemic, advances in medical tech, climate change and urbanization, increased diagnostics, testing, and reporting
Histology and direct exam
GMS(silver stain) or periodic acid-schiff(PAS)
GMS(silver stain)
targets carbohydrates, appears black/brown on light green
periodic acid-schiff(PAS)
targes polysaccharides, glycoproteins, red/pink/purple
histology pros and cons
see pathologic effect but not sensitive, cant do susceptibilities, difficult to ID species
culture pros and cons
specific and can do susceptibility, not very sensitive and takes time
antigen testing pros and cons
fairly fast but varied specificity and sensitivity, no susceptibility testing
PCR pros and cons
specifc but no susceptibility and difficult to distinguish colonization from pathogen
serology pros and cons
specifc but not good in immunocompromised patients, difficult to distinguish colonization or past exposure vs clinical disease
cutaneous and subcutaneous mcyoses
high incidence and generally non fatal, antifungals target ergosterol(azoles, terbinafine)

Pityriasis versicolor presentation
fairly common, nosocomial, causes altered pigmentation, seborrheic dermatitis, dandruff
Pityriasis versicolor treatment
topical or oral azoles
Malassezia spp
basidiomycete, normal skin flora that infects oily areas of skin, lipophilic, dimorphic, cause of Pityriasis versicolor


tinea negra presentation
rare, causes painless brown/black macules on hands and feet, occurs after contact with aqueous environment or in tropical/subtropical areas
tinea nigra treatment
dandruff shampoo, topical antifungals
Hortaea werneckii
ascomycete, causes tinea nigra

white piedra presentation
uncommon, causes white nodules on hair that can surround and invade the hair shaft, can leads to trichosporonosis, common in temperate, humid, or tropic climates
white piedra treatment
cut hair, topical/oral azoles
Tirchosporon spp
basidiomycete, no teleomorph state, yeast is hyphal form with septa
dermatophytes
group of molds that infect keratinous tissue, rare cause of dissemination disease except for immunocompromised
Trychophyton rubrum, Microsporum canis, Epidermophyton floccosum
trichosporonosis
disseminated white piedra that can occur in severely immunocompromised
Tinea capitis
hair shaft and scalp
Tinea barbae
skin and facial hair
tinea corporis
ringworm
tinea cruris
groin, “jock itch”
tinea pedis
athlete’s foot
tinea unguium
nails, “onychomycosis”
diagnosis for tineas
skin scraping for KOH, microscopy, culture
Trichophyton rubrum
ascomycete, most common dermatophyte, anthropophilic, has diffusible red pigment, can produce penicillin
Trichophyton rubrum conidia
microconidia: teardrop shaped
macroconidia: cigar shaped with thin walls

Microsporum canis
ascomycete, zoophilic(corporis and capitis)
Microsporum canis conidia
microconidia: rare
macroconidia: spindle shaped with thick walls

Epidermophyton floccosum
ascomycete, anthropophilic
epidermophyton floccosum conidia
microconidia: none
macroconidia: club shaped, “beaver tail” or “raquet” hyphae

Tineas treatment
tricophyton, microsporum, epidermophyton
topical antifungals: azoles and terbinafine
tinea capitus treatment
oral terbinafine, azoles, griseofulvin
Onchyomycosis/tinea unguium treatment
oral terbinafine, may be months of treatment
subcutaneous mycoses
sporothrichosis, chromoblastomycosis
sporothrichosis
“rose handlers disease,” spreads from puncture site centrally, causes nodules and swelling of lymph nodes, causes primary pulmonary/disseminated if inhaled
sporothrichosis treatment
azoles, ampho b if severely ill, previously with potassium iodide or hyperthermia
chromoblastomycosis
caused by traumatic implantation of dematiaceous yeast-like organisms into skin or subcutaneous tissue, occurs in the tropics/subtropics and rural area
chromoblastomycosis presentation
causes warty dermatitis, ulcerated or crusted, “chromo”
chromoblastomycosis diagnosis
histology: brown walled, round, non budding fungal form, “copper pennies”

chromoblastomycosis treatment
prolonged antifungal treatment, may require surgery
systemic endemics
ascomycetes that are molds in the environment, inherently virulent and causes primary pulmonary infection, often asymptomatic with initial lung infection, lab hazards, risk based on geographic exposure
coccidioides location
endemic to sw US, Mexico, central and south America, now in WA
hyperendemic to central valley of CA and phoenix/tuscon AZ
coccidioides yeast/yeast like
arthroconidia is infectious unit from soil, looks like spherule with endospores

coccidioides disease
extracellular, acute valley fever, causes skin nodules, arthiritis, flu-like, usually self limited pneumonia
coccidioides frequency
60% asymp, less than 5% disseminate, less than 5% recur
coccidioides risk of dissemination
risk for immunocompromised and pregnancy
coccidioides diagnosis
serology and antigen tests, cultures as a mold at 25C
coccidioides treatment
usually no treatment, flu/itraconazole for immunocompromised, ampho for more serious or disseminated
coccidioides meningitis
coccidioides that can occur in immunocompetent, requires lifelong antifungals
histoplasma capsulatum location
hyperendemic to Mississippi and Ohio river valleys, other varieties hyperendemic to central US, in caves/bat droppings
histoplasma yeast/yeast like
dimorphic, oval yeasts with no capsule

histoplasma disease
intracellular in macrophages, inhaled conidia form yeasts and multiply within macrophages in the lung, can disseminate, usually self resolving acute respiratory but can cause calcified nodules in the lung
histoplasma frequency
90% asymp, risk of dissemination for AIDS, immunocompromised, and kids
histoplasma diagnosis
blood or urine antigen test
histoplasma treatment
itraconzaole for mild-mod with symptoms, mild dissemination, NOT involving CNS
ampho B for moderately severe/severe, dissemination or CNS
12 rule: at least 12 weeks for penumonia, at least 12 months for dissemination
blastomyces dermatitidis location
moist soil, wooded areas, hyperendemic to mississippi and ohio st. lawrence river valleys, AR, KY, WI, hunters and outdoor work
blastomyces yeast/yeast like
dimorphic, lollipop conidia, broad based budding yeast

blastomyces disease
extracellular, inhalation of conidia results in clinical pulmonary infection and robust immune response, cutaneous disease if traumatic inoculation
blastomyces diagnosis
sputum or lung culture, can do an antigen but it could cross react, serology NOT useful
blastomyces treatment
treat everyone due to high rate of dissemination and severe disease, ampho B in serious and CNS, itraconazole for more mild symptoms
paracoccidioides location
central and south america
paracoccidioides yeast/yeast like
mariner’s wheel

paracoccidioides disease
extracellular
10% acute diease with quick progression: fever, weight loss, organomegaly, bone marrow dysfunction
90% chronic/reactivation disease: more common in males(estrogen), involves lungs and mucosa